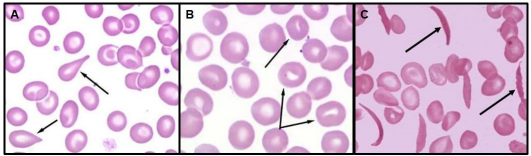
Enunciado 3685038-1

Foram encontradas 30 questões.
A leucemia é uma condição hematológica caracterizada pela produção descontrolada de células
sanguíneas anormais na medula óssea. Essas células anômalas prejudicam a produção saudável de
glóbulos vermelhos, brancos e plaquetas. Um(a) biomédico(a) está analisando os achados laboratoriais
de um paciente de 40 anos com suspeita de leucemia e visualiza na lâmina de distensão de sangue
periférico uma leucocitose com vários estágios da granulocitopoese. O hemograma revelou uma
contagem de leucócitos de 520 x 103
/ μL. Além disso, um cariótipo do paciente usando hibridização
fluorescente in situ (FISH) revelou a presença do cromossomo Filadélfia. Todos esses achados são
indicadores de
Provas
Questão presente nas seguintes provas
Os eritrócitos desempenham papel vital no transporte de oxigênio, mas várias condições podem afetar
sua morfologia e função. Compreender essas alterações é fundamental para o diagnóstico e manejo de
doenças hematológicas. Sendo assim, analise a lâmina a seguir.

Fonte: https://images.app.goo.gl/BYXxrLwYeE6CjvGg9; https://images.app.goo.gl/ZQGu8W5DTPhgJ9u48; https://images.app.goo.gl/cvs6ivr83vZ1V2cC9
Ao analisar a lâmina de distenção de sangue periférico, as células apontadas em A, B e C representam, respectivamente,
Fonte: https://images.app.goo.gl/BYXxrLwYeE6CjvGg9; https://images.app.goo.gl/ZQGu8W5DTPhgJ9u48; https://images.app.goo.gl/cvs6ivr83vZ1V2cC9
Ao analisar a lâmina de distenção de sangue periférico, as células apontadas em A, B e C representam, respectivamente,
Provas
Questão presente nas seguintes provas
O infarto, uma das manifestações mais graves da doença cardíaca, é desencadeado pela interrupção do
suprimento sanguíneo para uma parte do coração. Durante um infarto do miocárdio, algumas enzimas
cardíacas específicas são liberadas no sangue devido ao dano das células do músculo cardíaco. Essas
enzimas são marcadores úteis para diagnosticar e avaliar a extensão do dano cardíaco. O gráfico a seguir
apresenta o comportamento de alguns desses biomarcadores.

Adaptado de: https://www.cardiofamilia.org/apuntes-de-cardiologia/cardiopatia-isquemica/infarto-demiocardio-cardiopatia-isquemica/marcadores-de-necrosis.html
As letras e setas correspondem, respectivamente, a

Adaptado de: https://www.cardiofamilia.org/apuntes-de-cardiologia/cardiopatia-isquemica/infarto-demiocardio-cardiopatia-isquemica/marcadores-de-necrosis.html
As letras e setas correspondem, respectivamente, a
Provas
Questão presente nas seguintes provas
A acidose respiratória é um distúrbio clínico causado pela hipoventilação, levando a uma concentração
aumentada da pressão de dióxido de carbono arterial (hipercapnia). A hipercapnia e a acidose respiratória
ocorrem quando
Provas
Questão presente nas seguintes provas
O cinetoplasto é uma estrutura presente no Trypanosoma cruzi, o parasita responsável pela doença de
Chagas. Localiza-se na mitocôndria, contém uma quantidade significativa de DNA, chamado de DNA
cinetoplástico (kDNA), e organiza-se em redes circulares. O cinetoplasto desempenha um papel vital no
metabolismo energético do parasita, sendo essencial para a produção de ATP. Além disso, o kDNA tem
sido usado no estudo da variabilidade genética do T. cruzi, visando aprimorar técnicas de diagnóstico
molecular. Para isso, é ampliado um gene do kDNA por PCR (polymerase chain reaction), seguindo para
uma etapa com digestão enzimática e consecutiva visualização do padrão de bandas por eletroforese.
Essa importante técnica de genotipagem denomina-se
Provas
Questão presente nas seguintes provas
Analise a imagem abaixo que representa estruturas de um parasito. Ele possui um complexo ciclo de vida
no hospedeiro humano, necessitando de um estágio de maturação nos pulmões.

Adaptado de: https://parasitologiaclinica.ufsc.br/index.php/info/conteudo/fotografias
Considerando o ciclo de vida desse parasito, é correto afirmar que

Adaptado de: https://parasitologiaclinica.ufsc.br/index.php/info/conteudo/fotografias
Considerando o ciclo de vida desse parasito, é correto afirmar que
Provas
Questão presente nas seguintes provas
A gonadotrofina coriônica humana beta é uma substância produzida durante a gravidez, sendo um
marcador fundamental para detectar a gestação. Analise, a seguir, os testes de B-HCG de quatro
pacientes: A, B, C e D.

Adaptado de: http://ebram.com/assets/606.intuse.pdf
Com base em seus conhecimentos sobre a interpretação de testes rápidos, é correto afirmar que

Adaptado de: http://ebram.com/assets/606.intuse.pdf
Com base em seus conhecimentos sobre a interpretação de testes rápidos, é correto afirmar que
Provas
Questão presente nas seguintes provas
Durante um plantão no banco de sangue, foram solicitados testes de compatibilidade para um bebê que
necessitava receber concentrado de hemácias pela primeira vez, pois seu hemograma revelou Hb de
6,5g/dL e Ht 33%. Sendo assim, avalie o resultado dos testes.
Adaptado de: https://saude.rs.gov.br/upload/arquivos/carga20190515/03151546-testes-pre-transfusionais.pdf
A partir do resultado apresentado, deve se concluir que o RN e a mãe são do tipo sanguíneo
Adaptado de: https://saude.rs.gov.br/upload/arquivos/carga20190515/03151546-testes-pre-transfusionais.pdf
A partir do resultado apresentado, deve se concluir que o RN e a mãe são do tipo sanguíneo
Provas
Questão presente nas seguintes provas
O microscópio é um equipamento de laboratório fundamental para as análises clínicas sendo utilizado em
diversas áreas como microbiologia, parasitologia, hematologia, uroanálises e imunologia. Para a leitura
do sedimento urinário, o analista clínico deve, a princípio,
Provas
Questão presente nas seguintes provas
No diagnóstico microbiológico clínico, diversos meios de cultivo são utilizados para o crescimento
bacteriano. Sobre os meios de cultura, O ágar
Provas
Questão presente nas seguintes provas
Cadernos
Caderno Container